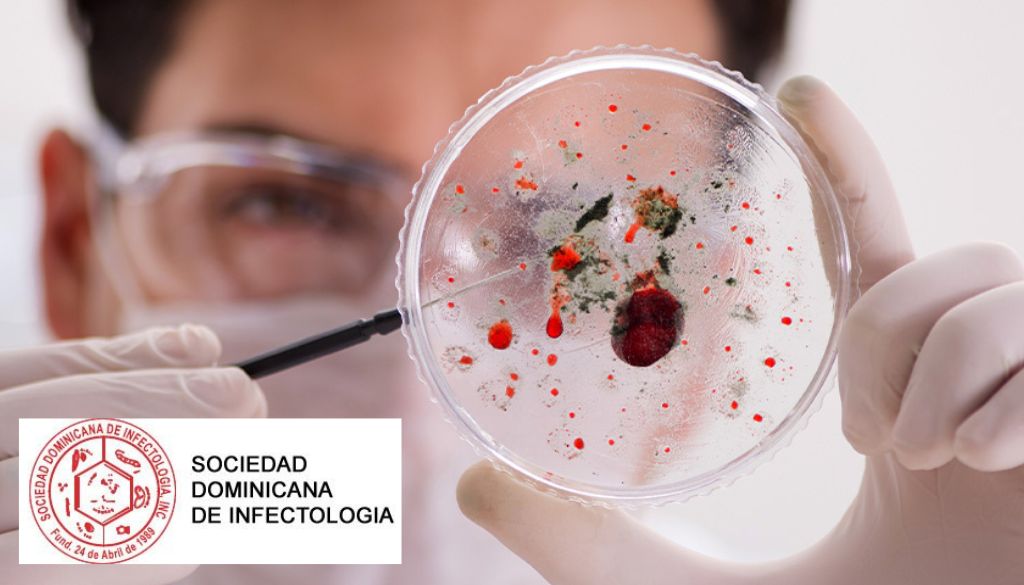

Filiales Norte de Infectología y Urología realizan su primer encuentro intersociedades

La Sociedad Dominicana de Infectología, Filial Norte, y la Sociedad Dominicana de Urología, Filial Norte, realizaron el Primer Encuentro Intersociedades bajo el tema “Nuevo enfoque de las infecciones del tracto urinario”. La Sociedad Dominicana de Infectología, Filial Norte, agradeció la valiosa participación de la doctora Arantxa Rodríguez, conferencista invitada, por compartir sus conocimientos y contribuir […]
Sociedad Infectología abordará el uso responsable de antibióticos

La Sociedad Dominicana de Infectología invita al encuentro “Prescribir con evidencia, auditar con impacto”, donde especialistas compartirán herramientas experiencias sobre el uso responsable de antibióticos. La actividad está pautada para el 29 de noviembre de 9:00 a.m., a 4:00 p.m., en el Hotel Marriott Courtyard. Para más detalles comuníquese a través del 809-255-0121 y/o con […]
Alertan resistencia bacteriana ya está en los ríos del país

La Sociedad Dominicana de Infectología expresó su preocupación ante los recientes hallazgos del Instituto de Innovación en Biotecnología e Industria (IIBI) y universidades aliadas como COMONIINTEC, ISFODOSU e ISA, quienes mediante análisis genómico avanzado detectaron la presencia de bacterias resistentes a antibióticos en ríos importantes de la República Dominicana. Entre los ríos afectados se encuentran […]
Advierten importancia vacunación contra Hepatitis B desde el nacimiento

La Sociedad Dominicana de Infectología (SDI) llamó la atención sobre la importancia de aplicar la vacuna contra la Hepatitis B desde el nacimiento, como medida esencial para proteger a nuestros bebés contra una enfermedad que puede convertirse en crónica y traer graves complicaciones. Mediante un comunicado, la entidad explicó que la infección por el virus […]
Revista Microbiota extiende fecha para recepción de manuscritos

La Sociedad Dominicana de Infectología informó que la revista Microbiota extendió la fecha límite para la recepción de manuscritos correspondientes al Volumen 4, edición agosto 2025. Los interesados en participar tienen ahora hasta el 31 de agosto de 2025 para enviar sus trabajos. Se aceptarán artículos originales, revisiones sistemáticas, informes especiales, opiniones, análisis y temas […]
Presidenta de Sociedad de Infectología se pronuncia ante caso sospechoso de “bacteria come carne” en el país

A propósito de la reciente sospecha de un caso de infección por Vibrio vulnificus en el país —conocida popularmente como la “bacteria come carne” por su capacidad de causar infecciones cutáneas graves y de rápida evolución— la doctora Yori Roque, presidenta de la Sociedad Dominicana de Infectología informa que el Ministerio de Salud Pública ha […]
Infectólogos juramentan nueva directiva para el periodo 2025-2027

La Sociedad Dominicana de Infectología (SDI) llevó a cabo el acto de juramentación de su nueva directiva para el período 2025–2027. El evento marcó un momento significativo para la institución, al asumir como presidenta la Dra. Yori Roque, quien previamente se desempeñaba como coordinadora de la filial norte. La acompañan los doctores Héctor Balcácer como […]
Sociedad de Infectología elige nueva directiva

La Sociedad Dominicana de Infectología llevó a cabo su Asamblea Ordinaria, en la cual fue elegida la nueva directiva que estará al frente de la institución durante el período 2025–2027. Esta nueva directiva está conformada por un destacado equipo de profesionales, quienes asumen con entusiasmo y compromiso la responsabilidad de continuar fortaleciendo el desarrollo científico, […]
Congresos médicos destacan excelencia profesional con reconocimientos a especialistas

Importantes sociedades médicas especializadas desarrollaron de manera simultánea, este fin de semana, sus congresos, en los que reunieron a expertos nacionales e internacionales, propiciando un espacio no solo para la actualización médica, el intercambio de experiencias y la promoción de tecnologías emergentes, sino también para reconocer a destacados especialistas. En este contexto, la Sociedad Dominicana […]
Inician hoy los congresos nacionales de importantes sociedades médicas

Este jueves, Punta Cana será el escenario donde expertos nacionales e internacionales se darán cita para participar en dos importantes congresos nacionales organizados por reconocidas sociedades médicas especializadas del país. Ambos eventos tienen como eje central la actualización científica de sus miembros y la presentación de las últimas tendencias en sus respectivas áreas. Se trata […]
Sociedades médicas acogen nuevos miembros con presentaciones de alto nivel

Con el objetivo de promover la integración, fortalecer y ampliar su membresía, así como fomentar la actualización continua de sus profesionales, dos sociedades médicas especializadas llevaron a cabo sus jornadas de integración para nuevos miembros. La Sociedad Dominicana de Neurología y Neurocirugía (SDNN) y la Sociedad Dominicana de Infectología (SDI) fueron las encargadas de la […]
Sociedad Infectología define prioridades para salud pública en nuevo año
Dra. Rosa Abreu, presidenta de la Sociedad Dominicana de Infectología Consideraciones del año 2024 Como Sociedad Dominicana de Infectología, durante este año 2024, que finaliza, continuamos cumpliendo con nuestro compromiso con la Educación Médica Continua y el fortalecimiento de la salud de nuestro país, compromiso que asumimos además para este nuevo año 2025. Como país […]
Semana de la Concienciación sobre la resistencia a los antimicrobianos

18-24 de Noviembre 2024 Educar. Promover. Actuar ahora. Por: Dra. Rosa Abreu, presidenta SDI La resistencia a los antimicrobianos surge cuando las bacterias, los virus, los hongos y los parásitos cambian a lo largo del tiempo y dejan de responder a los medicamentos, lo que hace más difícil el tratamiento de las infecciones e incrementa […]
Sociedad Dominicana de Infectología lanza boletín número 12

La Sociedad Dominicana de Infectología ha lanzado su Boletín Vol. 12 correspondiente al mes de septiembre de 2024. El mismo destaca importantes avances y actualizaciones en el campo de las enfermedades infecciosas. Este boletín es una fuente clave de información para los profesionales de la salud en República Dominicana, proporcionando acceso a las últimas investigaciones, […]
Sociedad de Infectología y Parlacen firman acuerdo para impulsar educación en salud

En un paso significativo hacia el fortalecimiento de la salud pública, la Sociedad Dominicana de Infectología (SDI) y la Comisión de Salud del Parlamento Centroamericano (Parlacen) firmaron un acuerdo de colaboración para mejorar la educación e intervención en salud en la región. Este acuerdo tiene como objetivos clave la prevención de enfermedades, el fortalecimiento de […]
Infectólogos del Norte anuncian su próxima jornada

La Sociedad Dominicana de Infectología se prepara para celebrar su V Jornada Filial Norte los días 13 y 14 de septiembre en el Centro de Convenciones UTESA de Santiago. Bajo el tema central de «Emergencias y re-emergencias«, este evento reunirá a destacados conferencistas nacionales e internacionales para abordar los últimos avances en el campo de […]
